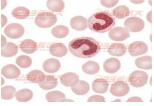

|
診斷學(xué)
|
|
| 細(xì) 胞 | 細(xì) 胞 | 百分率(%) | 絕對(duì)值(×109/L) |
| 中性桿狀核粒細(xì)胞(Nst) | 0.01~0.05 | 1~5 | 0.04~0.50 |
| 中性分葉核粒細(xì)胞(Nsg) | 0.50~0.70 | 50~70 | 2.00~7.00 |
| 嗜酸性粒細(xì)胞(E) | 0.005~0.050 | 0.5~5 | 0.05~0.50 |
| 嗜堿性粒細(xì)胞(B) | 0~0.01 | 0~1 | 0~0.01 |
| 淋巴細(xì)胞(L) | 0.20~0.40 | 0.20~0.40 | 0.80~4.00 |
| 單核細(xì)胞(M) | 0.03~0.08 | 3~8 | 0.12~0.80 |
白細(xì)胞總數(shù)與中性粒細(xì)胞數(shù)量增多及減少的參考標(biāo)準(zhǔn)
| 疾 病 | 參考標(biāo)準(zhǔn) |
| 白細(xì)胞增多 | 外周血白細(xì)胞>10×109/L |
| 白細(xì)胞減少 | 外周血白細(xì)胞<4.0×109/L |
| 中性粒細(xì)胞增多癥 | 外周血中性粒細(xì)胞絕對(duì)值>7.0×109/L |
| 粒細(xì)胞減少癥 | 外周血中性粒細(xì)胞絕對(duì)值:成人<2.0×109/L;兒童<1.5×109/L |
| 粒細(xì)胞缺乏癥 | 外周血白細(xì)胞<2.0×109/L,中性粒細(xì)胞絕對(duì)值<0.5×109/L或消失 |
1、中性粒細(xì)胞:
(1)中性粒細(xì)胞生理性變化:白細(xì)胞或中性粒細(xì)胞生理性增多一般多為暫時(shí)性,去除影響因素后則可恢復(fù)正常。這種變化與內(nèi)分泌因素有關(guān),主要是由于邊緣池的白細(xì)胞進(jìn)入循環(huán)池增多所致。增多的粒細(xì)胞大多為成熟的中性分葉核粒細(xì)胞,淋巴細(xì)胞和單核細(xì)胞也增加,通常不伴有白細(xì)胞質(zhì)量的改變。白細(xì)胞的生理性波動(dòng)很大,白細(xì)胞計(jì)數(shù)結(jié)果在30%以內(nèi)波動(dòng)多無意義,只有通過定時(shí)和連續(xù)觀察才有診斷價(jià)值。
(2)中性粒細(xì)胞增多:中性粒細(xì)胞病理性增多的原因很多,大致上可歸納為兩大類:反應(yīng)性增多和異常增生性增多。
1)反應(yīng)性增多:是機(jī)體對(duì)各種病理因素刺激產(chǎn)生應(yīng)激反應(yīng),動(dòng)員骨髓貯存池的粒細(xì)胞釋放及(或)邊緣池的粒細(xì)胞進(jìn)入循環(huán)池所致。因此,增多的粒細(xì)胞大多為成熟的分葉核粒細(xì)胞或較為成熟的桿狀核粒細(xì)胞。反應(yīng)性白細(xì)胞(中性粒細(xì)胞),急性感染及炎癥是中性粒細(xì)胞增多最常見的原因,增多的程度與病原體的種類、感染的部位、范圍和嚴(yán)重程度以及機(jī)體的反應(yīng)性有關(guān)。絕大多數(shù)細(xì)菌感染的白細(xì)胞為(10~30)×109/L,白細(xì)胞超過30×109/L提示深部感染或腹膜炎,超過50×109/L時(shí)提示感染嚴(yán)重。
白細(xì)胞(中性粒細(xì)胞)反應(yīng)性增高病因

感染程度與白細(xì)胞變化關(guān)系
| 嚴(yán)重程度 | 白細(xì)胞 | 中性粒細(xì)胞 | 原 因 |
| 局部輕微感染 | 可正常 | 略增高 | |
| 中等程度感染 | 增高 | 增高,伴輕度核左移及毒性改變 | 機(jī)體反應(yīng)性良好,骨髓細(xì)胞釋放入血 |
| 嚴(yán)重感染 | 顯著增高 | 增高,伴明顯核左移及毒性改變 | 機(jī)體反應(yīng)性良好,骨髓細(xì)胞釋放入血 |
| 極重感染 | 減低 | 減低,明顯核左移及毒性改變 | 機(jī)體反應(yīng)性差,WBC大量聚集于內(nèi)臟血管及炎癥局部,預(yù)后差 |
某些嚴(yán)重急性感染者可出現(xiàn)類白血病反應(yīng),需與白血病相鑒別。類白血病反應(yīng)是機(jī)體對(duì)某些刺激因素所產(chǎn)生的類似白血病表現(xiàn)的血象反應(yīng)。當(dāng)刺激因素去除后,類白血病反應(yīng)也逐漸消失。類白血病反應(yīng)根據(jù)外周白細(xì)胞總數(shù)的多少可分為白細(xì)胞增多性(多見)和白細(xì)胞不增多性2種。根據(jù)增多的細(xì)胞類型可分為中性粒細(xì)胞型、嗜酸性粒細(xì)胞型等。
2)異常增生性增多:系造血干細(xì)胞克隆性疾病,為造血組織中粒細(xì)胞大量異常增生并釋放到外周血所致,增多的粒細(xì)胞主要是病理性粒細(xì)胞或未成熟粒細(xì)胞,常伴其他系細(xì)胞改變,如紅細(xì)胞或血小板增多或減少。異常增生性增多主要見于:
a、白 血 。合翟煅到y(tǒng)惡性腫瘤,因造血組織中病理性白細(xì)胞大量異常增生并釋放到外周血所致。常見于急性、慢性粒細(xì)胞白血。绷、慢粒)。
b、骨髓增殖性疾病(MPD):為一組多能干細(xì)胞病變引起的疾病。
急性、慢性粒細(xì)胞白血病白細(xì)胞鑒別
| 鑒 別 點(diǎn) | 急 性 | 慢 性 |
| 骨髓細(xì)胞 | 以原始及(或)幼稚白血病細(xì)胞增多為主,非紅系有核細(xì)胞(NEC)常>30% | 以較成熟病理性白細(xì)胞增高為主。在慢粒,WBC常>100×109/L(早期無癥狀患者可<50×109/L) |
| 外周血細(xì)胞 | WBC增高者不到50%,一般為(10~50)×109/L,超過100×109/L者較少 | 粒細(xì)胞占90%以上,以中幼及晚幼粒細(xì)胞為主,原粒細(xì)胞<10%,伴嗜酸性、嗜堿性粒細(xì)胞增多 |
骨髓增殖性疾病特點(diǎn)
| 疾 病 | 特 點(diǎn) |
| 真性紅細(xì)胞增多癥 | WBC可達(dá)20×109/L,伴輕度核左移,出現(xiàn)特征性紅細(xì)胞增多和血小板增多 |
| 原發(fā)性血小板增多癥 | WBC(10~30)×109/L,血小板異常增多,常>1 000×109/L,伴形態(tài)異常 |
| 骨髓纖維化 | WBC可達(dá)50×109/L,伴“幼紅-幼!痹龆 |
(3)中性粒細(xì)胞減少:引起中性粒細(xì)胞減少的機(jī)制主要有:①中性粒細(xì)胞增殖和成熟障礙。②中性粒細(xì)胞在血液或組織中消耗或破壞過多。③中性粒細(xì)胞分布異常。引起中性粒細(xì)胞減少的病因很多,其臨床表現(xiàn)亦隨著病因及粒細(xì)胞減少的嚴(yán)重程度而不同。當(dāng)粒細(xì)胞計(jì)數(shù)小于1.0×109/L時(shí),極易發(fā)生感染;當(dāng)粒細(xì)胞計(jì)數(shù)小于0.5×109/L(急性粒細(xì)胞缺乏癥)時(shí),嚴(yán)重感染和疾病復(fù)發(fā)的危險(xiǎn)性增加;颊叱霈F(xiàn)發(fā)熱、咽痛、口腔潰瘍等感染癥狀,甚至引起敗血癥。臨床上應(yīng)根據(jù)病史鑒別是粒細(xì)胞缺乏引起的感染,還是嚴(yán)重感染所致的粒細(xì)胞缺乏。在理化因素?fù)p傷中,藥物誘導(dǎo)性中性粒細(xì)胞減少最常見,年發(fā)病率約為(3~4)/106,兒童及年輕患者約占10%,老年患者約占50%。
中性粒細(xì)胞減少的原因及機(jī)制
| 類別 | 原因 | 機(jī)制 |
| 感染 | 病毒、革蘭陰性桿菌(傷寒)、某些原蟲感染等,病毒感染是最常見的原因 | 病毒、細(xì)菌內(nèi)毒素和異體蛋白使大量粒細(xì)胞轉(zhuǎn)至邊緣池及抑制骨髓釋放粒細(xì)胞,亦與抗感染消耗增多有關(guān)。 |
| 血液病 | 再生障礙性貧血、PNH、非白血性白血病、骨髓轉(zhuǎn)移癌、巨幼細(xì)胞性貧血 | 造血干細(xì)胞功能障礙、粒細(xì)胞增殖異;驙I(yíng)養(yǎng)缺乏導(dǎo)致骨髓粒細(xì)胞生成、成熟障礙或無效生成 |
| 理化損傷 | 放射線、苯、鉛、汞以及化學(xué)藥物等 | 直接損傷造血干細(xì)胞或抑制骨髓粒細(xì)胞有絲分裂,直接或通過抗原或抗原抗體復(fù)合物破壞白細(xì)胞 |
| 脾功能亢進(jìn) | 脾淋巴瘤、脾血管瘤、肝硬化、門靜脈或脾靜脈栓塞、心衰、類脂質(zhì)沉積病 | 粒細(xì)胞被脾臟滯留、吞噬;脾臟產(chǎn)生某些體液因子,抑制骨髓造血或加速血細(xì)胞破壞 |
| 自身免疫疾病 | ITP、AIHA、新生兒同種免疫性粒細(xì)胞減少癥、SLE、類風(fēng)濕性關(guān)節(jié)炎 | 與機(jī)體可能存在白細(xì)胞的自身抗體導(dǎo)致破壞增多有關(guān) |
引起中性粒細(xì)胞減少的藥物
| 類別 | 藥物 |
| 鎮(zhèn)痛抗炎藥 | 氨基比林、保泰松、對(duì)乙酰氨基酚、鎮(zhèn)痛新、吲哚美辛、復(fù)方阿司匹林、非那西丁、金鹽 |
| 抗 生 素 | 氯霉素、頭孢菌素、青霉素、鏈霉素、慶大霉素、異煙肼、利福平、對(duì)氨基水楊酸 |
| 磺 胺 藥 | 磺胺、磺胺嘧啶、磺胺甲噁唑、磺胺-6-甲氧嘧啶、磺胺甲氧吡嗪、磺胺噻唑 |
| 抗糖尿病藥 | 氯磺丙脲、甲苯磺丁脲 |
| 抗甲狀腺藥 | 卡比馬唑、丙基硫氧嘧啶、甲硫咪唑 |
| 抗 癌 藥 | 環(huán)磷酰胺、白消安、甲氨蝶呤、氟尿嘧啶、長(zhǎng)春新堿、氮芥、別嘌醇、秋水仙素 |
| 抗瘧疾藥 | 奎寧、伯氨喹啉、撲瘧喹啉 |
| 抗抑郁藥 | 多慮平、去憂敏、阿米替林、丙米嗪 |
| 鎮(zhèn)靜、催眠藥 | 苯巴比妥、氯氮、戊巴比妥鈉、氯氮平 |
| 降壓利尿藥 | 依他尼林、汞利尿劑、雙氫克尿塞、乙酰唑胺、氨苯蝶啶、甲基多巴 |
| 心血管藥 | 卡托普利、奎尼丁、普魯卡因胺、托卡胺、氟卡胺 |
| 其他 | 有機(jī)砷、安非他明、青霉胺、苯海拉明、普魯卡因、維甲酸、甲硝唑 |
2、嗜堿性粒細(xì)胞(B): 是由髓系干細(xì)胞分化為嗜堿性粒細(xì)胞祖細(xì)胞(CFU-B)后發(fā)育而來的,在骨髓及外周血中的數(shù)量很少(0~1%)。其形態(tài)和功能與肥大細(xì)胞相似, 主要參與超敏反應(yīng)。嗜堿性粒細(xì)胞計(jì)數(shù)常用于慢性粒細(xì)胞白血病與類白血病反應(yīng)的鑒別以及觀察變態(tài)反應(yīng)。
(1)嗜堿性粒細(xì)胞增多:外周血嗜堿性粒細(xì)胞絕對(duì)值>0.1×109/L。
嗜堿性粒細(xì)胞增多的臨床意義
| 類別 | 臨床意義 |
| 過敏性和炎 | 食物、藥物、吸入性過敏性反應(yīng);潰瘍性結(jié)腸炎、蕁麻疹、紅皮病、風(fēng)濕 |
| 癥性疾病 | 性關(guān)節(jié)炎等,可伴有白細(xì)胞或中性粒細(xì)胞增多 |
| 嗜堿性粒細(xì)胞白血病 | 為一種少見類型的急性白血病。白細(xì)胞數(shù)可正;蛟龈撸葔A性粒細(xì)胞可達(dá)30%~80%,伴幼稚型增多 |
| 骨髓增殖性疾病 | 慢粒、真性紅細(xì)胞增多癥、原發(fā)性骨髓纖維化、原發(fā)性血小板增多癥等。嗜堿性粒細(xì)胞輕度增高,可作為骨髓增殖性疾病一個(gè)早期征象。外周血嗜堿性粒細(xì)胞達(dá)10%~20%,是慢粒的特征之一,若嗜堿性粒細(xì)胞突然>20%,預(yù)示病情惡化 |
| 內(nèi)分泌疾病 | 糖尿病、甲狀腺功能減退癥、雌激素治療等 |
| 其他 | 重金屬(如鉛、汞、鉻等)中毒、系統(tǒng)性肥大細(xì)胞增多癥、放射線照射,反映某些感染性疾。ㄈ缢、結(jié)核病)等 |
(2)嗜堿性粒細(xì)胞減少:嗜堿性粒細(xì)胞數(shù)量很少,其減少與否難以察覺,多無臨床意義。減少可見于過敏性休克、促腎上腺皮質(zhì)激素或糖皮質(zhì)激素應(yīng)用過量以及應(yīng)激反應(yīng)等。
3、淋巴細(xì)胞(L):由骨髓多能造血干細(xì)胞分化為淋巴系干細(xì)胞后分化發(fā)育而來。淋巴細(xì)胞主要分為T細(xì)胞、B細(xì)胞和自然殺傷細(xì)胞三大類。淋巴細(xì)胞是人體主要的免疫細(xì)胞,觀察其數(shù)量變化,有助于了解機(jī)體的免疫功能狀態(tài),采用淋巴細(xì)胞直接計(jì)數(shù)比間接計(jì)數(shù)更有臨床價(jià)值。
(1)淋巴細(xì)胞增多:指外周血淋巴細(xì)胞絕對(duì)值增高(成人大于4.0×109/L;兒童:4歲以上大于7.2×109/L、4歲以下大于9.0×109/L)。淋巴細(xì)胞數(shù)量受某些生理因素的影響,如午后和晚上比早晨高;出生1周后嬰兒淋巴細(xì)胞可達(dá)50%以上,可持續(xù)至6~7歲,后逐漸降至成人水平。
淋巴細(xì)胞病理性增多的原因和意義


4、單核細(xì)胞(M):來自骨髓多能造血干細(xì)胞分化的髓系干細(xì)胞和粒-單核系祖細(xì)胞。成人單核細(xì)胞占白細(xì)胞總數(shù)3%~8%。骨髓釋放入外周血的單核細(xì)胞為成熟的單核細(xì)胞,在血液中停留3~6d,即逸出血管進(jìn)入組織或體腔內(nèi),經(jīng)5~9d,發(fā)育為巨噬細(xì)胞,形成單核-巨噬細(xì)胞系統(tǒng),防御功能增強(qiáng)。
正常兒童外周血單核細(xì)胞可較成人稍高,平均為9%;2周內(nèi)的嬰兒可達(dá)15%或更多;妊娠中、晚期及分娩亦可增多,均為生理性增多。單核細(xì)胞增多是指成人外周血單核細(xì)胞絕對(duì)值大于0.8×109/L。單核細(xì)胞病理性增多的原因和意義見表2-44。單核細(xì)胞減低意義不大。
單核細(xì)胞病理性增多的原因和意義
5、嗜酸性粒細(xì)胞計(jì)數(shù):嗜酸性粒細(xì)胞(E)起源于骨髓多能造血干細(xì)胞的髓系干細(xì)胞分化的嗜酸性粒細(xì)胞祖細(xì)胞(CFU-EO)。嗜酸性粒細(xì)胞集落形成因子主要由受抗原刺激的淋巴細(xì)胞產(chǎn)生,因此,嗜酸性粒細(xì)胞與免疫系統(tǒng)關(guān)系密切。嗜酸性粒細(xì)胞主要存在于骨髓和組織中,外周血中很少,僅占全身嗜酸性粒細(xì)胞總數(shù)1%左右。因此,嗜酸性粒細(xì)胞經(jīng)外周血間接計(jì)算的絕對(duì)值誤差較大,要準(zhǔn)確地了解嗜酸性粒細(xì)胞的變化,應(yīng)采用直接計(jì)數(shù)法。
(1)參考值:(0.05~0.50)×109/L。
(2)臨床意義:正常人嗜酸性粒細(xì)胞早晨較低,夜間較高;上午波動(dòng)大,下午較恒定,波動(dòng)可達(dá)40%左右。白天交感神經(jīng)興奮,通過下丘腦刺激垂體前葉產(chǎn)生促腎上腺皮質(zhì)激素,進(jìn)而使腎上腺皮質(zhì)產(chǎn)生腎上腺皮質(zhì)激素,后者可抑制骨髓釋放嗜酸性粒細(xì)胞,并促使血中嗜酸性粒細(xì)胞向邊緣池和組織轉(zhuǎn)移,從而引起血循環(huán)中的嗜酸性粒細(xì)胞減少。勞動(dòng)、運(yùn)動(dòng)、饑餓、冷熱及精神刺激等,均可引起交感神經(jīng)興奮,使血循環(huán)中的嗜酸性粒細(xì)胞減少。
1)嗜酸性粒細(xì)胞增多:指成人外周血嗜酸性粒細(xì)胞絕對(duì)值大于0.5×109/L。①輕度增多:(0.5~1.5)×109/L。②中度增多:(1.5~5.0)×109/L。③重度增多:5.0×109/L。臨床上常見于過敏性疾病及寄生蟲感染,為T淋巴細(xì)胞介導(dǎo)的反應(yīng)性嗜酸性粒細(xì)胞增多;亦常見于某些惡性腫瘤、骨髓增殖性疾病。
嗜酸性粒細(xì)胞增多的原因及機(jī)制


2)嗜酸性粒細(xì)胞減低:指成人外周血嗜酸性粒細(xì)胞絕對(duì)值<0.05×109/L。主要見于:
A、傳染病急性期:一般病原體急性感染期,機(jī)體處于應(yīng)激狀態(tài),腎上腺皮質(zhì)激素分泌增加,嗜酸性粒細(xì)胞隨之減少,恢復(fù)期嗜酸性粒細(xì)胞又重新出現(xiàn)并逐漸增多。若癥狀嚴(yán)重而嗜酸性粒細(xì)胞不減少,說明腎上腺皮質(zhì)功能衰竭;若嗜酸性粒細(xì)胞持續(xù)減低,甚至消失,說明病情嚴(yán)重。因此,嗜酸性粒細(xì)胞計(jì)數(shù)可用于觀察急性傳染病的病情及預(yù)后判斷。
B、嚴(yán)重組織損傷:如手術(shù)后4h,嗜酸性粒細(xì)胞常顯著降低,24~48h后逐漸增多,增多的速度與病情變化基本一致。大面積燒傷患者,數(shù)小時(shí)后嗜酸性粒細(xì)胞完全消失,并持續(xù)較長(zhǎng)時(shí)間。若大手術(shù)或大面積燒傷后,嗜酸性粒細(xì)胞不減低或減低很少,表明預(yù)后不良。因此嗜酸性粒細(xì)胞計(jì)數(shù)可作為預(yù)后觀察的指標(biāo)。
C、判斷垂體或腎上腺皮質(zhì)功能:腎上腺皮質(zhì)激素、垂體或腎上腺皮質(zhì)功能亢進(jìn)時(shí),嗜酸性粒細(xì)胞減低,因此,可通過垂體或腎上腺皮質(zhì)刺激試驗(yàn),觀察嗜酸性粒細(xì)胞數(shù)量變化,判斷垂體或腎上腺皮質(zhì)的功能。四、白細(xì)胞形態(tài)檢查:血涂片染色后,各種類型白細(xì)胞的形態(tài)學(xué)特點(diǎn)各不相同。在病理狀態(tài)下,除白細(xì)胞計(jì)數(shù)和分類發(fā)生變化外,其形態(tài)有時(shí)也會(huì)發(fā)生改變。計(jì)算各種白細(xì)胞比例及觀察白細(xì)胞形態(tài)的變化,對(duì)診斷疾病和觀察療效具有重要的意義。白細(xì)胞形態(tài)學(xué)檢查主要是顯微鏡檢查法。
(一)正常白細(xì)胞形態(tài)特征


(二)中性粒細(xì)胞核形界定:分葉核粒細(xì)胞的核分葉之間,外觀以染色較深的一絲實(shí)線相連,因只有核膜組成,故其內(nèi)無染色質(zhì),此點(diǎn)是中性粒細(xì)胞分葉核與桿狀核鑒別的基礎(chǔ)。當(dāng)桿狀核與分葉核鑒別困難時(shí),可將其歸類于分葉核。
(三)粒細(xì)胞胞質(zhì)內(nèi)顆粒:中性粒細(xì)胞的胞質(zhì)內(nèi)顆粒分為嗜天青顆粒(占20%)和特殊顆粒(占80%)。
粒細(xì)胞顆粒的比較

(一)中性粒細(xì)胞毒性變化:在嚴(yán)重的化膿性感染、敗血癥、惡性腫瘤、急性中毒、大面積燒傷等病理情況下,中性粒細(xì)胞可發(fā)生一系列形態(tài)改變。這些形態(tài)變化對(duì)判斷預(yù)后有一定意義。
1、大小不均:中性粒細(xì)胞的體積大小相差懸殊,不均一性增大。常見于病程較長(zhǎng)的化膿性感染,與內(nèi)毒素等因素作用于骨髓內(nèi)早期中性粒細(xì)胞,使其發(fā)生頓挫性不規(guī)則分裂、增殖有關(guān)。

2、中毒顆粒:在嚴(yán)重感染及大面積燒傷等情況下,中性粒細(xì)胞的胞質(zhì)中出現(xiàn)比正常中性顆粒粗大、大小不等、分布不均的紫黑色或深紫褐色顆粒,稱中毒顆粒。可能與特殊顆粒生成過程受阻或顆粒變性造成2~3個(gè)嗜天青顆粒融合有關(guān)。含中毒顆粒的細(xì)胞在中性粒細(xì)胞中所占的比值稱為中毒指數(shù)。中毒指數(shù)愈大,感染、中毒情況愈嚴(yán)重。
(1)中毒顆粒較粗大且染色深,易與嗜堿性粒細(xì)胞的顆粒混淆。嗜堿性粒細(xì)胞胞核分葉較少,顆粒大而不均,染色更深,可分布在胞核上而使胞核分葉不清。
(2)中毒顆粒數(shù)量少、分布稀疏散在于正常中性顆粒之間時(shí),應(yīng)注意辨認(rèn)。
(3)血涂片染色偏堿或染色時(shí)間過長(zhǎng),可造成正常的中性粒細(xì)胞顆粒染色過深,易與中毒顆;煜,此時(shí)應(yīng)注意血涂片的整體染色情況以幫助分辨。


3、空泡形成:中性粒細(xì)胞的胞質(zhì)或胞核可出現(xiàn)1個(gè)或數(shù)個(gè)空泡。是細(xì)胞發(fā)生脂肪變性或顆粒缺失的結(jié)果,常見于嚴(yán)重感染、敗血癥等。EDTA抗凝儲(chǔ)存血中的細(xì)胞也可出現(xiàn)退行性空泡,此時(shí),除非同時(shí)伴有其他中毒性形態(tài)改變,否則不宜將空泡變性歸因于中性粒細(xì)胞的毒性變。

4、杜勒小體:中性粒細(xì)胞因毒性變化而在胞質(zhì)中保留的局部嗜堿性區(qū)域(源自RNA),呈圓形、梨形或云霧狀,染天藍(lán)色或灰藍(lán)色,直徑0.1~2μm,最大可達(dá)5μm,單個(gè)或多個(gè),常位于細(xì)胞邊緣,超微結(jié)構(gòu)顯示,為粗面內(nèi)質(zhì)網(wǎng)組成,與正常染色區(qū)域界限模糊,是胞質(zhì)局部不成熟即核質(zhì)發(fā)育不平衡的表現(xiàn)。常見于嚴(yán)重感染,如肺炎、麻疹、敗血癥和燒傷等。

5、退行性變:退行性變是細(xì)胞發(fā)生胞體腫大、結(jié)構(gòu)模糊、邊緣不清晰、核固縮、核腫脹和核溶解(染色質(zhì)模糊、疏松)等現(xiàn)象,常見于衰老和病變的細(xì)胞。
中性粒細(xì)胞退行性變
(二)棒狀小體:白細(xì)胞胞質(zhì)中出現(xiàn)的紅色細(xì)桿狀物質(zhì),1個(gè)或數(shù)個(gè),長(zhǎng)約1~6μm,稱為棒狀小體(圖2-33),是初級(jí)嗜天青顆粒結(jié)晶化的形態(tài)。棒狀小體對(duì)鑒別急性白血病的類型有重要價(jià)值,主要見于急性粒細(xì)胞白血。ǘ嘁姡┖图毙詥魏思(xì)胞白血病(少見),而急性淋巴細(xì)胞白血病則無。
棒狀小體
(三)中性粒細(xì)胞的核象變化:核象標(biāo)志著中性粒細(xì)胞從新生細(xì)胞以至衰老細(xì)胞的發(fā)育階段。正常情況下,外周血中性粒細(xì)胞以分葉核為主,胞核常分為2~5葉,桿狀核較少,分葉核與桿狀核中性粒細(xì)胞的比值為13∶1。病理情況下,中性粒細(xì)胞的核象可發(fā)生核左移或核右移。

1、核 左 移:外周血中性桿狀核粒細(xì)胞增多或(和)出現(xiàn)晚幼粒、中幼粒甚至早幼粒細(xì)胞的現(xiàn)象稱為核左移。核左移是機(jī)體的一種反應(yīng)性改變,常見于化膿性感染、急性溶血以及應(yīng)用細(xì)胞因子,如粒細(xì)胞集落刺激因子或粒細(xì)胞巨噬細(xì)胞集落刺激因子等,并伴有中毒顆粒、空泡、退行性變等毒性變化。核左移常伴有白細(xì)胞總數(shù)增高,但白細(xì)胞總數(shù)也可正常甚至減低。核左移分為輕、中、重度三級(jí),與感染嚴(yán)重度和機(jī)體抵抗力密切相關(guān)。

(1)再生性核左移:核左移伴白細(xì)胞總數(shù)增高稱為再生性核左移,表示骨髓造血和釋放能力旺盛,機(jī)體抵抗力強(qiáng),多見于急性化膿性感染、急性中毒、急性溶血和急性失血。
(2)退行性核左移:核左移伴白細(xì)胞總數(shù)正;驕p低,表示骨髓釋放受到抑制,機(jī)體抵抗力差,見于再生障礙性貧血、粒細(xì)胞缺乏癥、傷寒等。
核左移類型及意義

2、核 右 移:外周血中性分葉核粒細(xì)胞增多,并且5葉核以上的中性粒細(xì)胞>3%時(shí)稱為核右移。近來,證明用分葉指數(shù)提示核右移更敏感,公式是:(5葉或更多葉中性粒細(xì)胞數(shù)量/4葉中性粒細(xì)胞的數(shù)量)×100;若值大于16.9則示異常,與血液分析儀檢測(cè)的平均過氧化物酶指數(shù)(MPXI)相關(guān)。核右移嚴(yán)重者常伴白細(xì)胞總數(shù)減少,反映造血功能衰退,與缺乏造血物質(zhì)、DNA合成障礙和骨髓造血功能減退有關(guān)。

核右移常見于巨幼細(xì)胞性貧血、內(nèi)因子缺乏所致的惡性貧血、感染、尿毒癥或骨髓異常綜合征等,應(yīng)用抗代謝藥物治療腫瘤時(shí)也會(huì)出現(xiàn)核右移。在炎癥恢復(fù)期,一過性核右移是正常現(xiàn)象,但在進(jìn)展期突然出現(xiàn)核右移是預(yù)后不良的征兆。
(四)中性粒細(xì)胞胞核形態(tài)的異常:
1、多分葉核中性粒細(xì)胞:成熟中性粒細(xì)胞胞體增大,核分葉5~9葉,甚至10葉以上,各葉大小差異很大,核染色質(zhì)疏松。常見于巨幼細(xì)胞性貧血、用抗代謝藥物治療后及惡性血液病等。
多分葉核中性粒細(xì)胞
多分葉核中性粒細(xì)胞
2、巨桿狀核中性粒細(xì)胞和巨多分葉核中性粒細(xì)胞:前者胞體可大至30μm,核染色質(zhì)略細(xì)致,著色變淺,胞核呈肥大桿狀或特長(zhǎng)帶狀。后者的胞核分葉超過5葉,常見于巨幼細(xì)胞性貧血和惡性貧血,也可見于MDS和白血病。
3、雙核粒細(xì)胞和環(huán)形桿狀核粒細(xì)胞:雙核粒細(xì)胞是中性粒細(xì)胞內(nèi)出現(xiàn)2個(gè)細(xì)胞核,環(huán)形桿狀核粒細(xì)胞是桿狀核呈環(huán)行。常見于骨髓增生異常綜合征(MDS)、粒細(xì)胞白血病及巨幼細(xì)胞性貧血(見環(huán)形桿狀核粒細(xì)胞)。
環(huán)形桿狀核粒細(xì)胞
環(huán)形桿狀核粒細(xì)胞
環(huán)形核中性粒細(xì)胞
(五)與遺傳因素相關(guān)的中性粒細(xì)胞畸形:與遺傳因素相關(guān)的中性粒細(xì)胞畸形有Chediak-Higashi畸形、Alder-Reilly畸形、May-Hegglin畸形、Pelger-Hüet畸形。
與遺傳因素相關(guān)的中性粒細(xì)胞畸形的形態(tài)特點(diǎn)和臨床意義


中性粒細(xì)胞異常形態(tài)新的分類為: ①細(xì)胞核異常:包括中性粒細(xì)胞桿狀核形成和核左移、中性粒細(xì)胞分葉核計(jì)數(shù)和核右移、中性粒細(xì)胞鼓槌小體和核突起、其他異常(核分葉過多、核分葉減少、環(huán)狀核、葡萄簇狀核)。②細(xì)胞質(zhì)異常:包括顆粒減少、顆粒增加、顆粒異常(Chediak-higashi、Alder-Reilly、May-Hegglin和Auer小體)、空泡、Döhle小體和類似包涵體、外源性中性粒細(xì)胞包涵體(微生物、冷球蛋白、瘧色素)。③細(xì)胞形態(tài)異常:包括巨大多分葉核白細(xì)胞、中性粒細(xì)胞漸進(jìn)性壞死(凋亡)、中性粒細(xì)胞聚集、中性粒細(xì)胞碎片
(六)淋巴細(xì)胞的形態(tài)異常:
1、異型淋巴細(xì)胞:在病毒(如腺病毒、人類皰疹病毒等)、原蟲(如弓形蟲)感染,藥物反應(yīng),結(jié)締組織疾病,免疫系統(tǒng)強(qiáng)應(yīng)激狀態(tài)或過敏原等因素刺激下,淋巴細(xì)胞增生并發(fā)生形態(tài)上的變化,表現(xiàn)為胞體增大、胞質(zhì)量增多、嗜堿性增強(qiáng)、細(xì)胞核母細(xì)胞化,稱異型淋巴細(xì)胞或反應(yīng)性淋巴細(xì)胞。外周血異型淋巴細(xì)胞主要是T細(xì)胞(83%~96%),少數(shù)為B細(xì)胞(4%~7%)。異型淋巴細(xì)胞按形態(tài)特征分為3型:Ⅰ型(空泡型)又稱泡沫型或漿細(xì)胞型(傳統(tǒng)認(rèn)為最常見),Ⅱ型(不規(guī)則型)又稱單核細(xì)胞型(現(xiàn)認(rèn)為最常見),Ⅲ型(幼稚型)又稱未成熟細(xì)胞型或幼淋巴細(xì)胞型。
異型淋巴細(xì)胞的形態(tài)特點(diǎn)



正常人外周血偶見異型淋巴細(xì)胞。異型淋巴細(xì)胞增多主要見于傳染性單核細(xì)胞增多癥(IM)、病毒性肝炎、流行性出血熱、濕疹等病毒性疾病和過敏性疾病。另外,E-B病毒、巨細(xì)胞病毒、艾滋病病毒、β-鏈球菌、梅毒螺旋體、弓形蟲等感染和接種疫苗也可引起外周血異型淋巴細(xì)胞增多。
2、衛(wèi)星核淋巴細(xì)胞:淋巴細(xì)胞主核旁有1個(gè)游離的衛(wèi)星小核。因染色體損傷,喪失著絲點(diǎn)的染色單體或其片段在有絲分裂末期未進(jìn)入子代細(xì)胞遺傳物質(zhì)體系內(nèi)而形成。常見于接受較大劑量電離輻射、核輻射之后或其他理化因素、抗癌藥物等造成的細(xì)胞損傷。常作為致畸、致突變的客觀指標(biāo)之一。



第二節(jié) 白細(xì)胞檢查